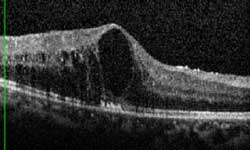

:次
北京大学人民医院眼科 曲进锋
今年的6月6日是第19个全国“爱眼日”,今年爱眼日的主题是“关注眼健康,预防糖尿病致盲”。
糖尿病会影响眼睛的各个部位,比如患者容易长麦粒肿、患结膜炎、角膜炎、泪囊炎、白内障、角膜上皮剥脱,还可能出现糖尿病视神经病变、糖尿病性眼肌麻痹。眼科手术以后出现伤口愈合不良、出血多、角膜水肿、角膜上皮损伤、眼内炎等并发症的危险也相应增加。
糖尿病视网膜病变(简称糖网)是糖尿病眼病中最严重的并发症,也是致盲的重要原因之一,在各种致盲眼病中约占8%。我国为糖尿病大国,2003年我国糖尿病发病率排世界第二,目前约有1000万糖尿病患者并发糖网,在大于40岁的糖尿病患者中,约有40%患有糖网。
(糖尿病视网膜病变的眼底表现)
哪些人容易患糖尿病视网膜病变?
发生糖网的危险因素中最主要的两点就是糖尿病病程和血糖控制情况。病程大于10年的患者中超过70%会出现不同程度的糖网,病程大于20年的患者中这一比例将超过90%。
糖化血红蛋白(HbA1C)每降低1%,糖网发生的风险将降低21%,进展的风险将降低43%,因此对于糖尿病患者来说最重要的就是控制好血糖,防止血糖波动,预防糖网的发生远比出现糖网后在进行治疗要重要得多。另外还有一些危险因素也会增加糖网发生的几率,比如高血压、高血脂、贫血、肾功能不全、妊娠、不良的生活习惯等。
怎样确定自己是否患有糖尿病视网膜病变呢?
糖尿病患者中老年人居多,当他们的眼睛有一些轻微改变时,常常误认为是因年龄而产生的衰退或者白内障。另外,糖网一般由视网膜中周部开始,早期对视力没有明显影响,可以没有任何症状,临床上有很多糖尿病患者就是因为没有症状所以从来没有进行过眼科检查,等到出现视力下降再来检查时已经进入了晚期,治疗困难而且效果也不好。
还有不少患者是因为出现了眼睛的问题,眼科医生怀疑由糖尿病引起,所以才去检查血糖,结果发现已经有非常严重的并发症了。因此我们建议糖尿病患者不要以是否看得清为标准到眼科就诊。
专家建议糖尿病患者确诊时就应立即到眼科进行眼底散瞳检查,如果检查出糖网表现,此后至少每3个月进行一次散瞳眼底检查;暂时没有出现糖网表现的患者也应当每年检查一次;妊娠期间的糖尿病患者无论眼底是否出现糖网表现,都应当每1—3个月进行一次散瞳眼底检查。
如果已经出现视力下降、眼前闪光感、眼前漂浮物、看东西变形、变小或者视物遮挡、眼红、眼疼等症状,就可能已经出现了糖尿病眼病,应尽快到眼科进行详细检查。
视力、眼压、裂隙灯检查和散瞳后的眼底检查是糖尿病患者应当进行的最基本的检查。由于糖网病变经常出现在视网膜周边部,在不散瞳的情况下很难发现,因此散瞳检查是非常必要的。通常医生会使用快速散瞳药,散瞳后患者会觉得看东西有些模糊和晃眼,但它的药效只维持五到八个小时,药效过后绝对不会影响您的视力 。
眼科的光学相干断层扫描(OCT)是一项无创的眼科检查,它对于早期发现糖尿病引起的黄斑水肿是非常有帮助的,往往比医生的肉眼判断更为准确。对于一些有视力下降或者视物变形的病人,如果怀疑存在黄斑水肿,OCT检查是必须的
还有一项常用的有创检查就是眼底荧光血管造影检查,它是根据造影观察眼底血管的情况,来发现肉眼难以看到的病变,比如血管渗漏、新生血管和视网膜缺血区。如果眼底病变已经达到一定的严重程度,医生往往会建议做眼底荧光血管造影检查,以便判断是否需要进行激光治疗。
总而言之,糖尿病患者应当定期进行眼科检查才能防患于未然,保护好视力。
(糖网患者的眼底荧光血管造影检查显示血管渗漏、新生血管和视网膜缺血区)
发生了糖尿病视网膜病变怎么治疗呢?
糖尿病视网膜病变的治疗取决于病变的严重程度。视网膜出现新生血管之前通常称之为背景期或者非增殖期糖网,视网膜出现新生血管之后通常称之为增殖期糖网。
轻到中度的非增殖期糖网可以保守治疗,口服一些改善微循环及保护神经的药物。重度的非增殖期糖网和增殖期糖网则需要全视网膜光凝。全视网膜光凝的目的是控制糖尿病视网膜病变的发展,但是全视网膜光凝后短期可能出现一过性的视力下降,也会对视野造成一定损害,但从长远看是有利于疾病的控制和视力维持的。因此把握激光治疗的时机对患者的预后非常重要。
对于出血量大或已引起视网膜脱离者需要进行玻璃体切除手术,帮助患者恢复和维持视力。出现白内障、青光眼等并发症时还需要进行相应的手术治疗。
(全视网膜光凝后的眼底)
糖尿病引起的黄斑水肿也是导致视力下降的一个主要原因,过去只有通过黄斑区的激光才能治疗黄斑水肿,但即便如此仍有约1/3的患者会在2年内发生视力下降。
近几年来,新出现的抗VEGF药物在治疗糖尿病性黄斑水肿方面取得了良好的疗效,能有效提高患者的视力,阻止视力下降,目前这种方法已经越来越多地取代了传统的激光治疗,成为了黄斑水肿的首选治疗方案。但是这一治疗的不足在于通常需要多次重复注射才能达到最佳的效果。
总而言之,糖尿病视网膜病变的治疗要在医生给您进行了全面评估后才能选择最佳的治疗方案。
(糖尿病引起的黄斑水肿)
(抗VEGF药物治疗黄斑水肿之后水肿完全消退)
给糖尿病患者的几点建议:
1.调整心态。目前尚无根治糖尿病的办法,因此必须面对现实,适应与糖尿病共存的生活,在战略上藐视它,在生活上重视它,调整生活习惯,定期进行正规的全面检查,把血糖、血压、血脂控制好!
2.坚定信心。正确及时的干预可以使得90%以上的糖尿病患者避免失明,而且新的治疗方法近几年也层出不穷,只要积极配合治疗,应当有信心能保护好自己的视力。
3.坚持不懈。糖尿病的治疗是一个长期的过程,不能指望看几次病就能看好,需要长期坚持不懈地配合医生的检查和治疗,不要讳疾忌医,错失了治疗的良机。